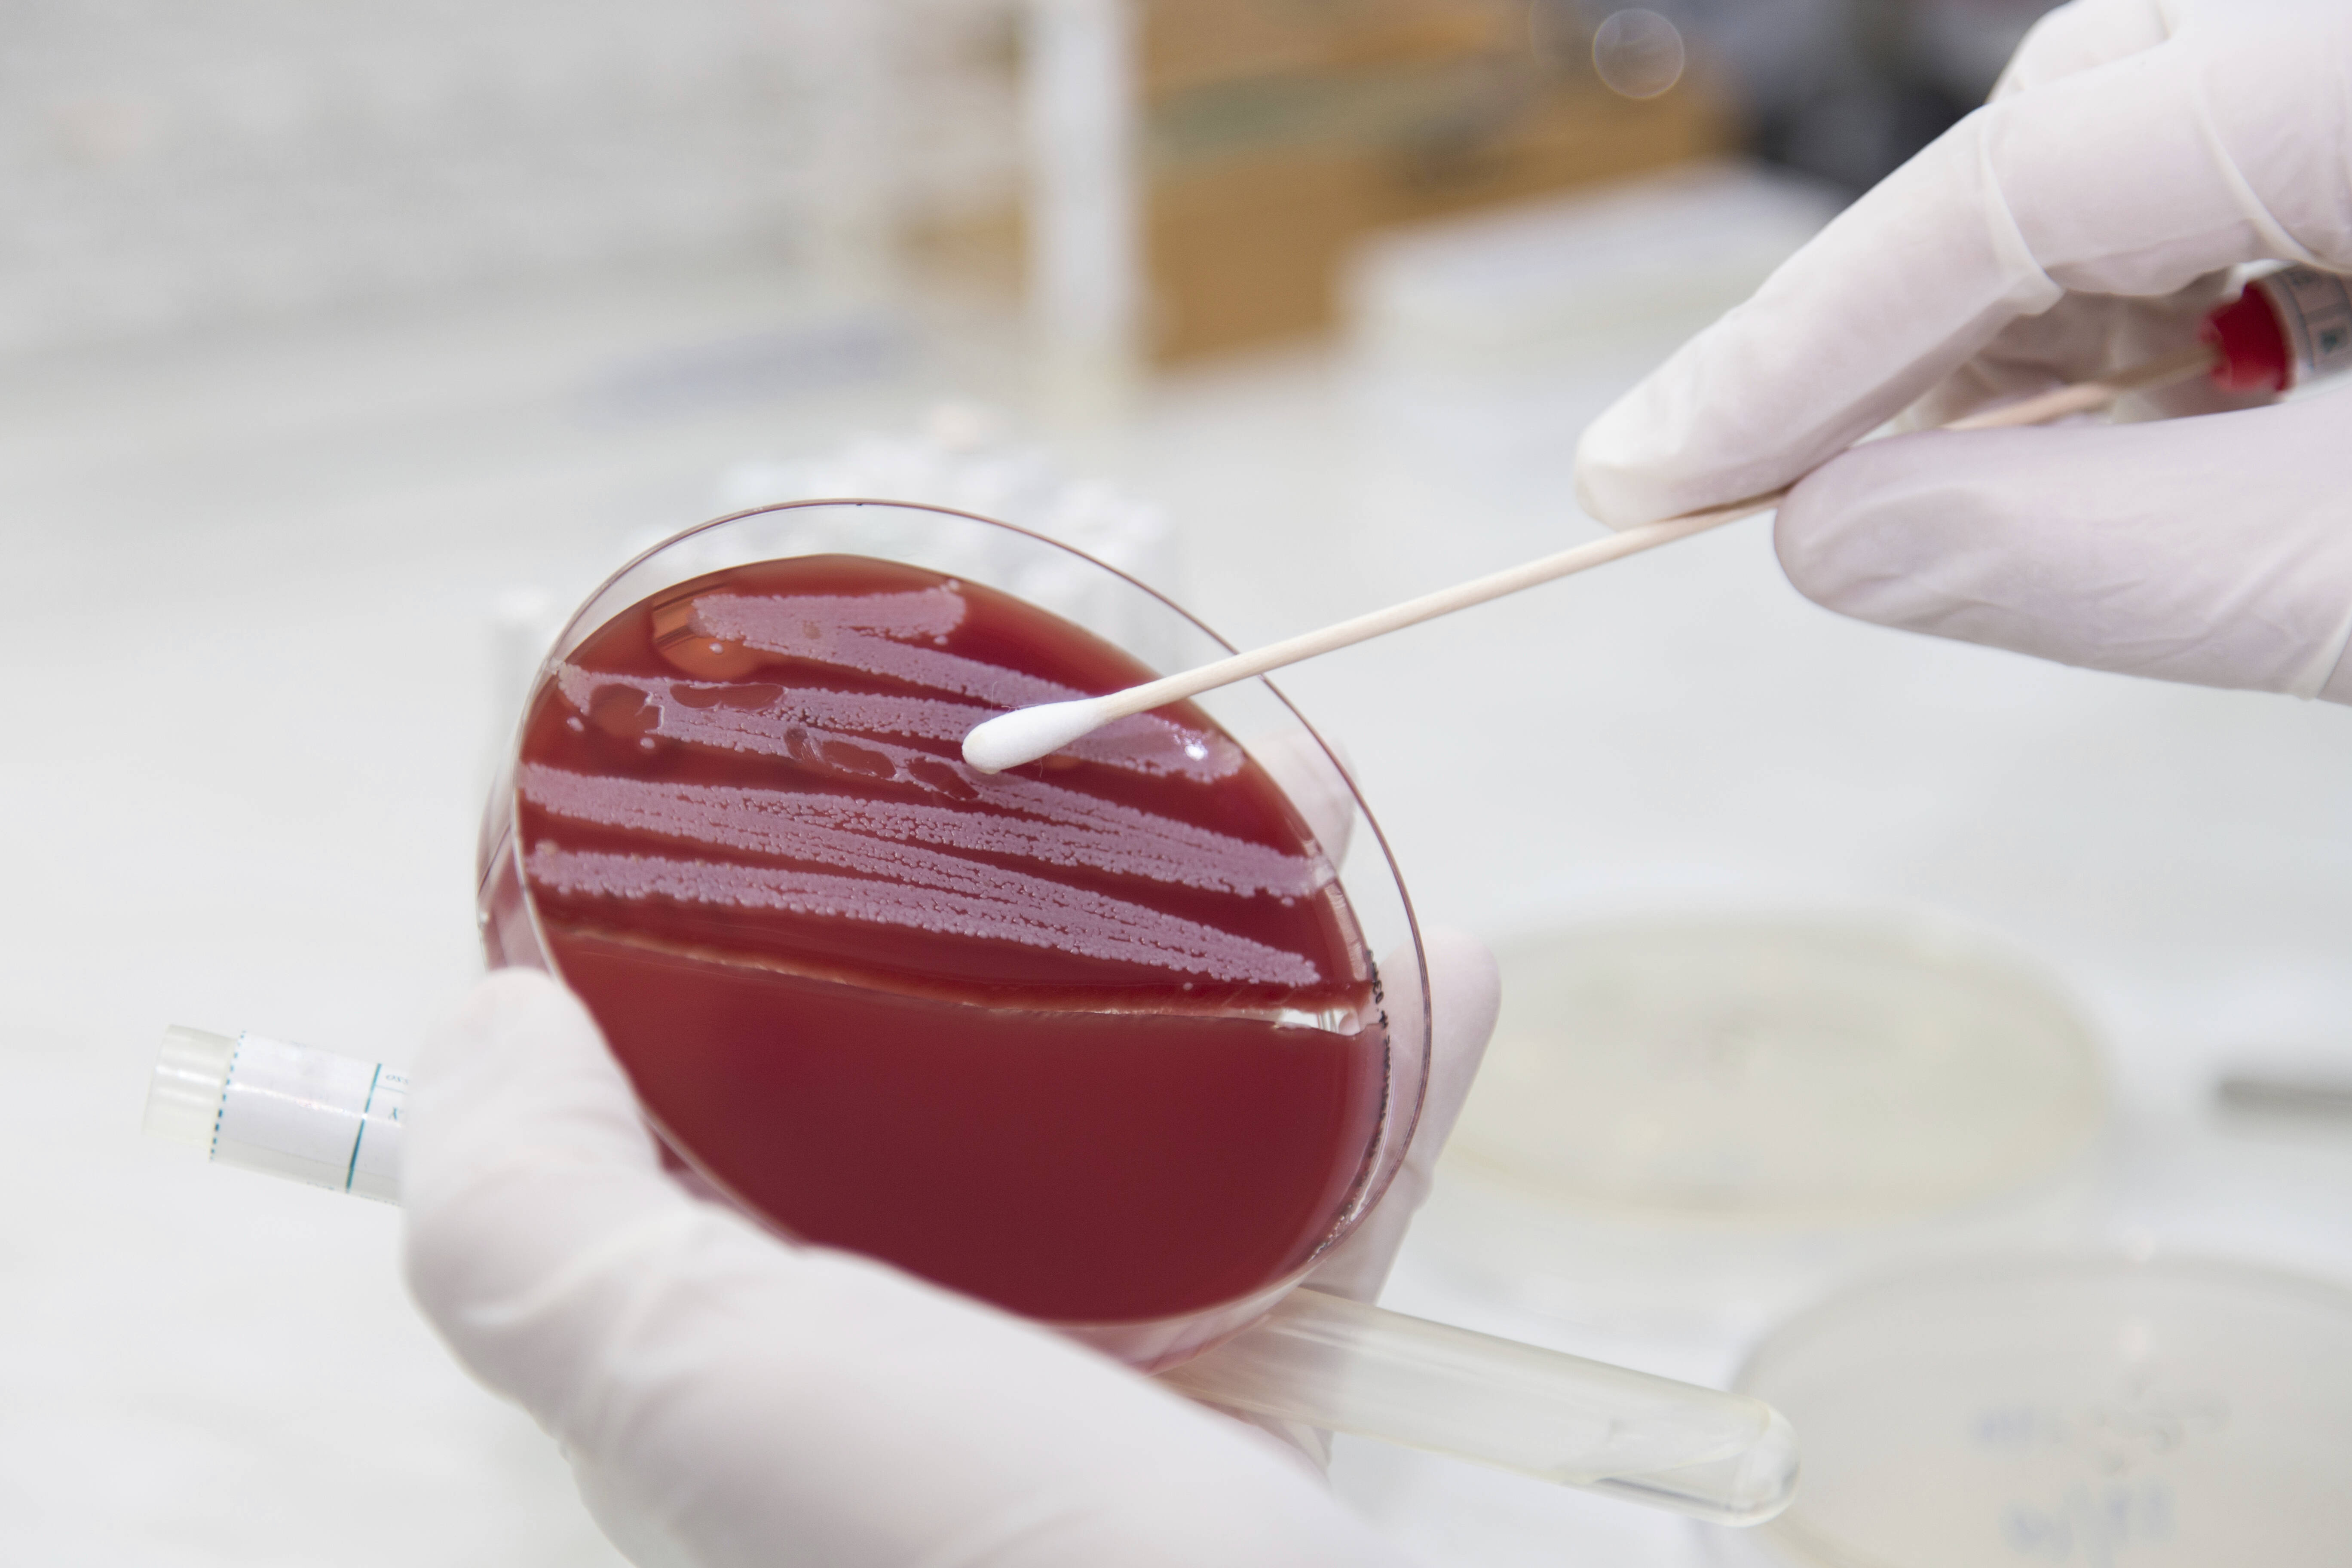

Mrsa Abstrich Kosten
Wir wurden gefragt wie der mrsa schnelltest abrechnet werden kann.
Mrsa abstrich kosten. Wie wird eine untersuchung auf mrsa durchgeführt. Bei diesem test kann durch den veranlassenden arzt auf jeden fall die abstrichentnahme nr. Um die trägerschaft auszuschließen muss eine mikrobiologische untersuchung in ei nem labor erfolgen. Zur mrsa diagnostik werden mit einem sterilen tupfer jeweils ein abstrich aus beiden nasenvorhöfen und dem rachen entnommen.
Zur laboruntersuchung selber ist zu beachten dass speziallaborleistungen nur von dem arzt berechnet werden können unter. Die gefühlten kosten einer mikrobiologischen untersuchung zum nachweis von mrsa sind höher als die realen kosten. Diesen hängen stark von der kalkulation des jeweiligen labors ab jedoch kann man von folgenden mittleren kosten von 3 bis 15 euro ausgehen. Schutz des betroffenen mrsa trägers.
Durch sanierung können signifikant infektionen verhindert werden perl tm et al 2002. Das bakterium lebt normalerweise auf der haut ohne probleme zu. Hierfür wird ein abstrich mit einem watte oder polyurethantupfer. Schnittlichen kosten eines solchen abstriches liegen bei ca.
Die kbv fordert bereits seit längerem dass ambulante ärztliche leistungen im zusammenhang mit einem prästationären mrsa screening vergütet werden. Ambulante mrsa versorgungambulante mrsa versorgung 8ambulante mrsa versorgung abrechnung und vergütung mrsa gop ablaufdiagramm für risikopatienten abstrich nach sanierung 30940 mrsa statuserhebung 309422 mrsa betreuung 30944 mrsa beratung 30950 bestätigung mrsa abstrich 30952 ausschluss mrsa abstrich legende v. 298 goä berechnet werden. Zusätzliche abstriche werden benötigt aus wunden gleich welcher art und von katheteraustrittsstellen.
Bislang übernehmen die krankenkassen die kosten nur für eine mrsa eradikationstherapie wenn diese nach einem krankenhausaufenthalt erfolgt und nicht schon davor. Ist die trägerschaft bekannt kann vor operation noch eine sanierung versucht werden. Wird ein mrsa nachgewiesen liegen die kosten bei ca. Durch abstrich e 19 punkte 30954 gezielter mrsa nachweis auf chromogenem selektivnährboden 51 punkte 30956 nachweis der koagulase und oder des clumpingfaktors zur erregeridentifikation nur bei positivem nachweis gemäß gop 30954 25 punkte gop im abschnitt 30 12 des ebm untersuchung nur für bestimmte.
Ein abstrich bei aufnahme hat daher dreifache bedeutung. N engl j med.